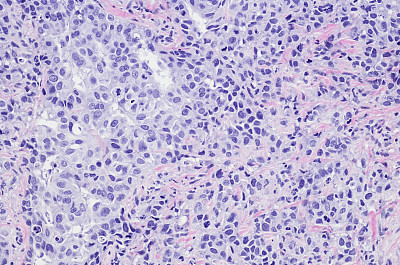

显微镜载玻片

请先登录后再下载
58明星,显微镜载玻片,实验室玻璃器皿,显微镜,实验室设备,医学样本,,微生物学,实验室,医学研究,生物学,科学实验,化学,科学,生物科技,医学检测,标本架,研究,,分析,设备用品,药,医疗器械,想法,工具,医疗用品,创新,健康保健,身体检查,放大效果,组物体,探索,生病,工业,科学样本,活组织检查,科技,白色,蓝色,巴西,概念,透明,空的,留白,玻璃,商业金融和工业,摄影,水平画幅,图像,4K分辨率